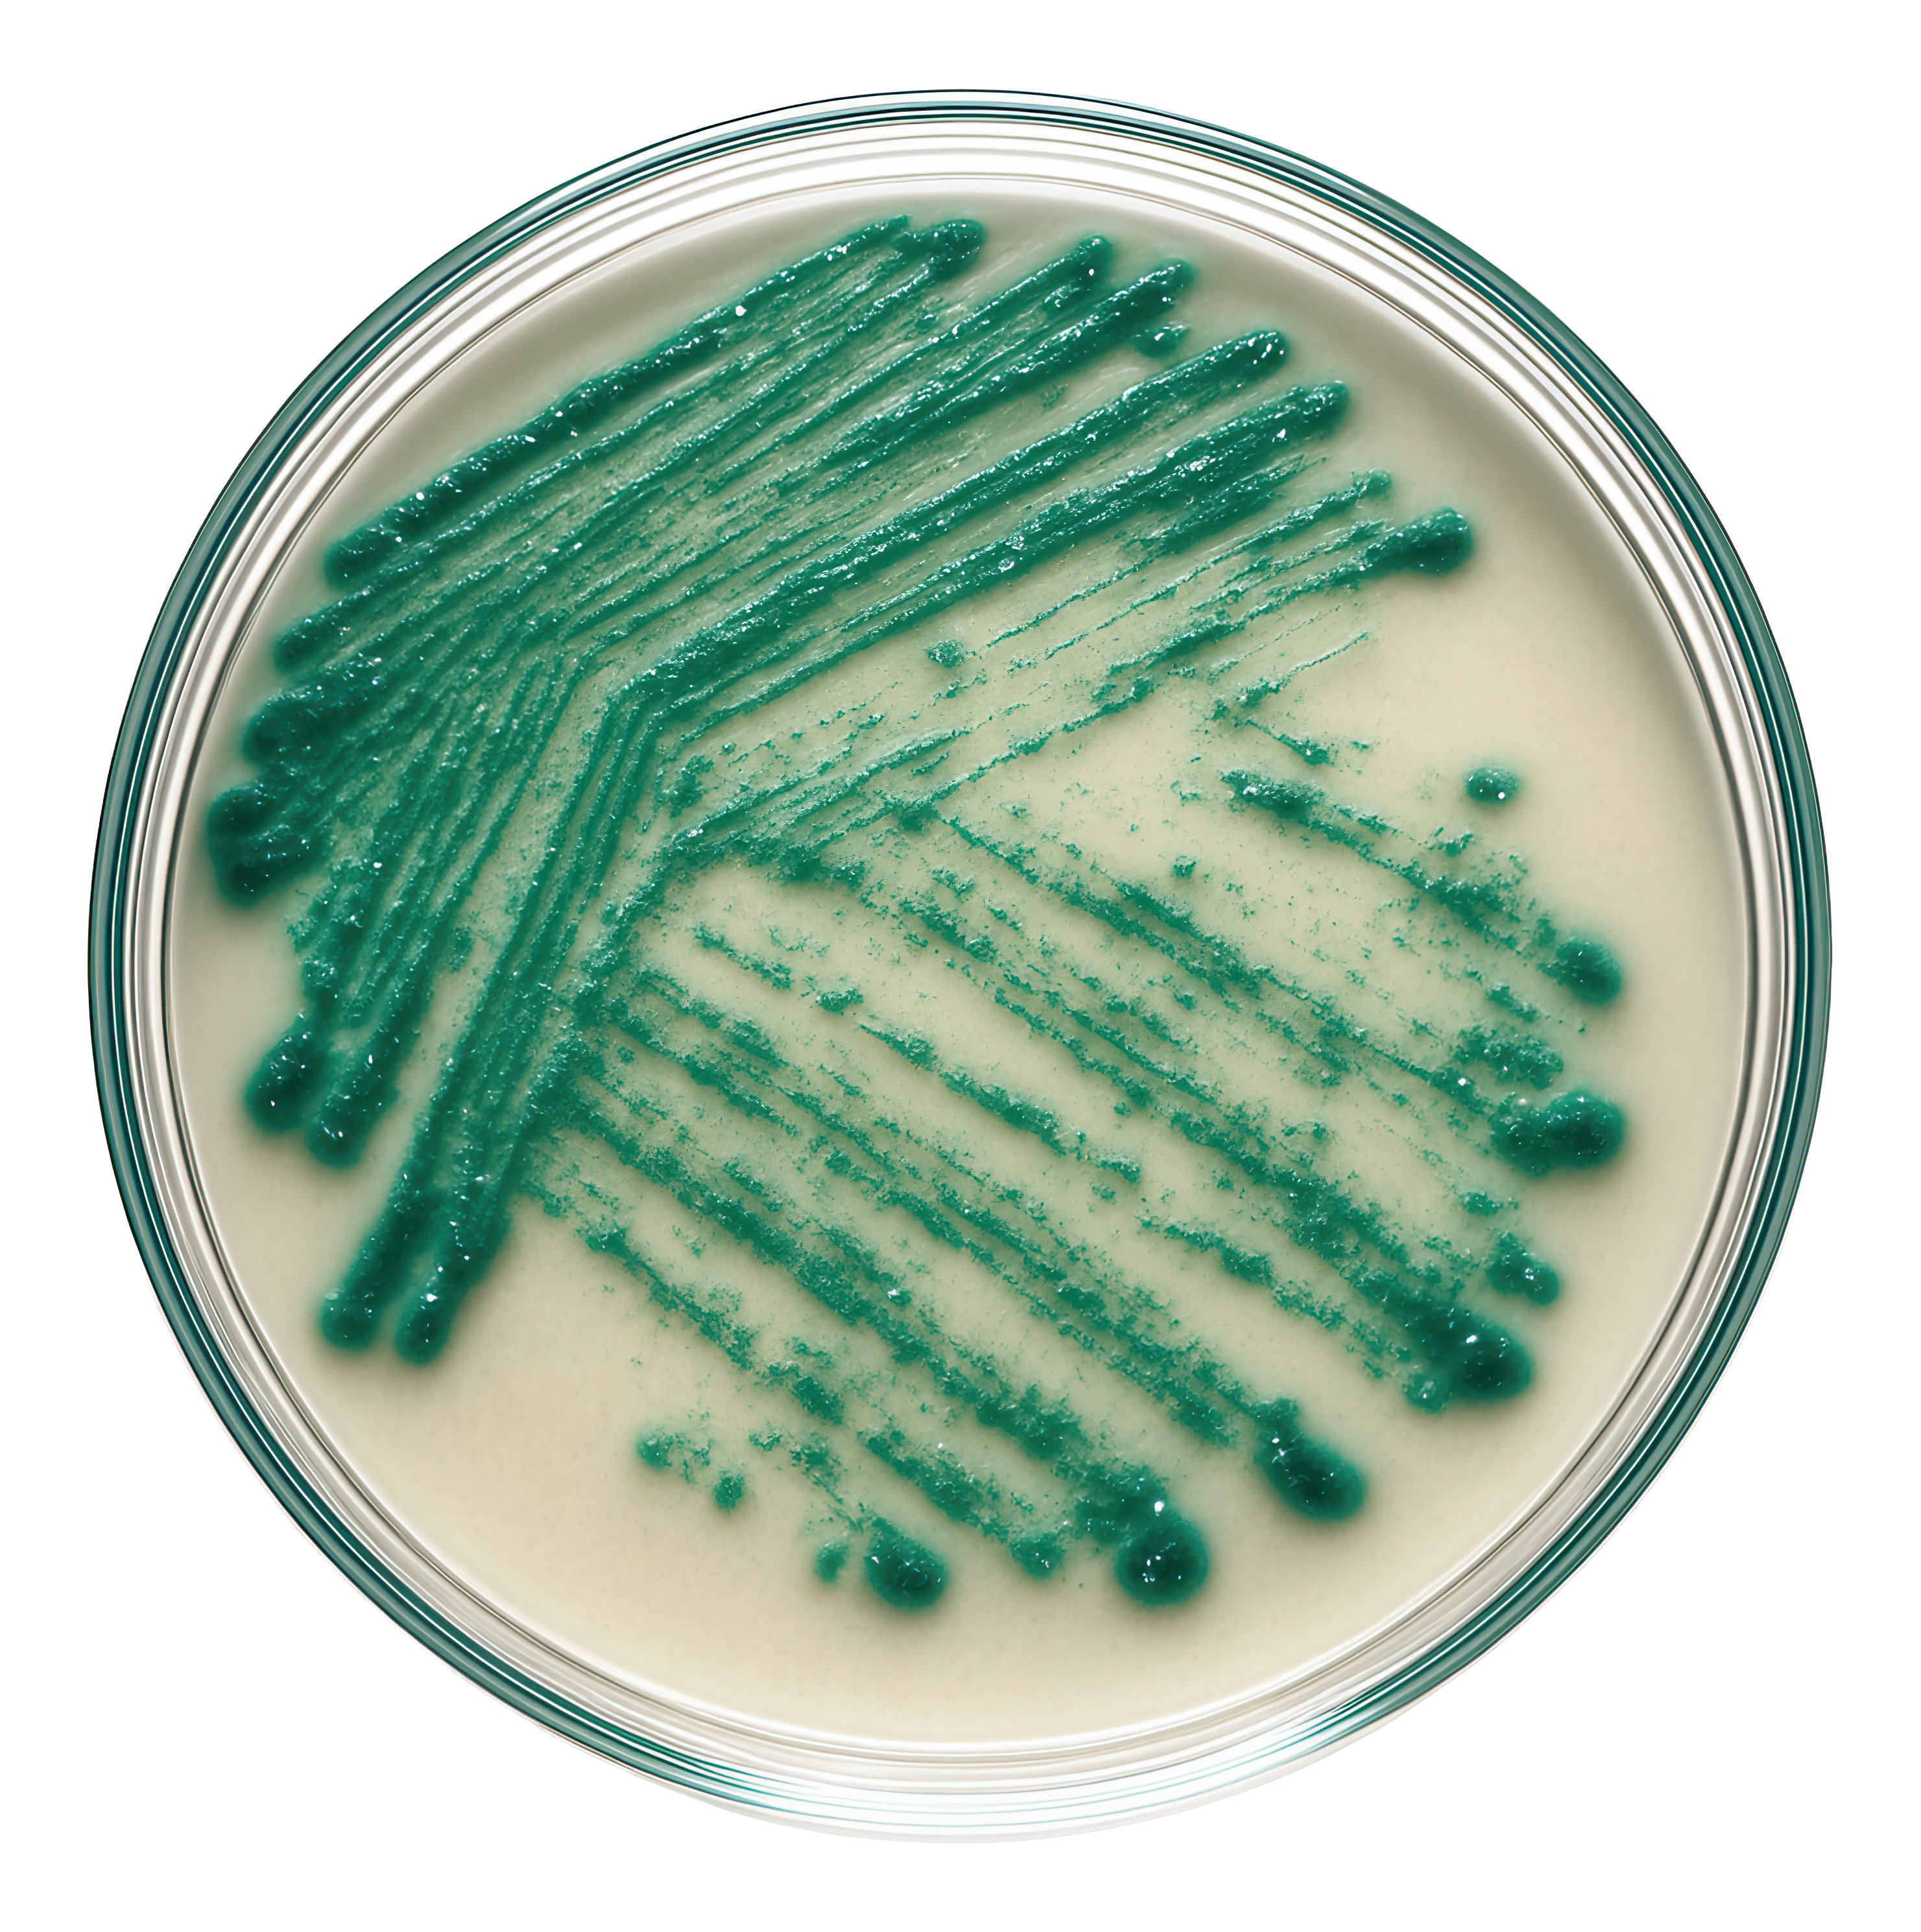
Entendiendo Pseudomonas: Biofilm y Mecanismos de Infección

Categoría: Bacterias
-
Acinetobacter baumannii: Patogenia y Mecanismos de Infección

Acinetobacter baumannii, un cocobacilo Gram negativo y oportunista, es relevante en UCI por su capacidad de sobrevivir en ambientes secos. Su patogenia está ligada a factores como cápsula, OmpA y biofilm, causando neumonía, bacteriemia y otras infecciones graves. La resistencia a antibióticos complica el tratamiento y requiere atención especial en los protocolos de prevención.
-
Entendiendo Pseudomonas: Biofilm y Mecanismos de Infección
Pseudomonas aeruginosa es un bacilo Gram negativo oportunista que alterna entre formas crónicas y agudas, utilizando biofilm y toxinas para patogenia. Su arsenal incluye quorum sensing y resistentes mecanismos, complicando el tratamiento. Comprender su patogenia y variantes clínicas es esencial para un diagnóstico y manejo efectivo en infecciones graves.
-
Yersinia: Patogenia y Mecanismos de Virulencia

El género Yersinia engloba tres especies: Y. pestis, causante de peste, y Y. enterocolitica y Y. pseudotuberculosis, responsables de enterocolitis. Compartiendo mecanismos de virulencia, cada patógeno presenta características clínicas distintivas. La comprensión de su patogenia, diagnósticos y aspectos de salud pública es esencial para su manejo y control efectivo.
-
Proteus, Morganella, Providencia.

Proteus, Morganella y Providencia (PMP) son bacilos Gram negativos que causan infecciones del tracto urinario (ITU) complicadas y otras patologías. Su virulencia se basa en ureasa, adhesinas y biofilm, con resistencia intrínseca a ciertos antibióticos. El manejo eficaz incluye control de foco, optimización de antimicrobianos y diagnóstico microbiológico adecuado.
-
Enterobacter, Serratia, Citrobacter.

Enterobacter, Serratia y Citrobacter: microbiología, patogenia, patotipos, toxinas y clínica | InfectoVega Enterobacter, Serratia y Citrobacter: patogenia, patotipos, toxinas y clínica 5 de octubre de 2025 · Lectura: 10–12 min · Por Dr. Agustín Vega Grupo ESCPM/SPACE con AmpC inducible: riesgo de fracaso si no se elige bien el antibiótico. Resumen Enterobacter, Serratia y Citrobacter…
